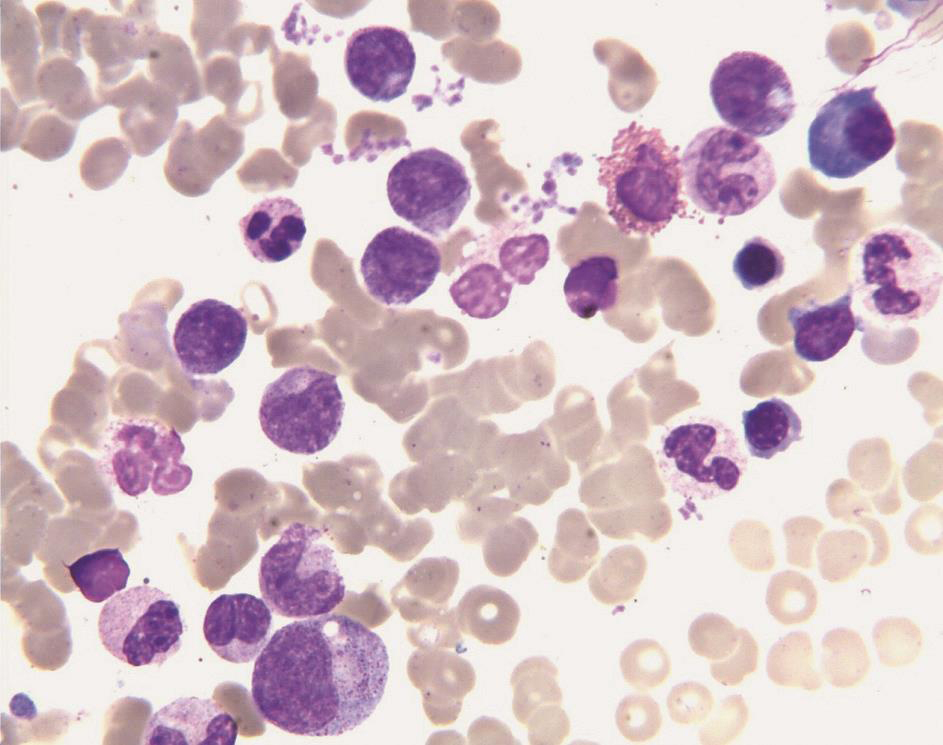

患者双耳疼痛、流脓、听力下降伴肺部占位病变,病因是什么?
56岁女性,双耳疼痛、流脓伴听力下降2个月,考虑为“急性化脓性中耳炎、周围性面神经麻痹(左侧)”,抗炎、抗感染治疗后,患者体温一度降至正常,双耳无流脓但仍有针刺样疼痛,听力下降、耳鸣,咳嗽、咳痰仍较明显,遂转风湿科住院进一步诊治。如何诊治?
一、病情摘要
1.基本情况
女性患者,56岁,以“双耳疼痛、流脓伴听力下降2个月”为主诉,于2016年2月入院。2个月前,患者无明显诱因出现双耳阵发性针刺样疼痛,流黄色脓液,伴耳鸣、听力下降、左侧面部麻木,后出现发热(体温最高达39.0℃),伴咳嗽、咳黄黏血丝痰,于我院耳鼻喉科就诊,考虑为“急性化脓性中耳炎、周围性面神经麻痹(左侧)”,予甲泼尼龙抗炎(120mg/d,3天后渐减量为40mg/d),并予头孢哌酮舒巴坦抗感染(3.0g,每8小时1次)。患者体温一度降至正常,双耳无流脓,但仍有针刺样疼痛,听力下降、耳鸣,咳嗽、咳痰仍较明显,遂转风湿科住院进一步诊治。
2.既往
体质健康,无吸烟及酗酒史,否认接触结核患者及禽类粪便。家族中无遗传性疾病患者。
3.入院查体
体温38.1℃,脉搏88次/min,呼吸20次/min,血压126/78mmHg。神志清楚,全身皮肤未见黄染,无出血点、皮疹。双侧颌下触及花生大小淋巴结,有触痛,质韧,活动度可。左侧额纹消失,左侧抬眉无力,左侧鼓腮漏气,露齿口角右偏,闭目双侧无留白。外耳道见少许黄色、黏稠的异常分泌物,乳突无压痛,听力粗测差。咽部有充血,少量淋巴滤泡增生,扁桃体Ⅰ度肿大,无充血、水肿。双肺呼吸音粗,可闻及少许细湿啰音。心律齐,未闻杂音。腹平软,无压痛、反跳痛,未触及明显包块,肝、脾肋下未触及肿大。双下肢无水肿,四肢关节无肿痛。病理征及脑膜刺激征阴性。
4.入院前检查
头部MRI(2016年2月2日):
①部分鼻窦炎,左侧上颌窦黏膜下囊肿;②双侧中耳乳突炎。
胸部CT(2016年2月3日):
右肺上叶尖段椭圆形密度增浓影,边界较清楚,呈浅分叶状,大小为1.3cm×2.1cm(图1)。

图1 胸部CT表现
电子支气管镜检查(2016年2月2日):
支气管镜下见气管黏膜糜烂(图2)。右中间支气管黏膜活检病理示支气管黏膜慢性炎症,鳞状上皮增生,黏膜糜烂坏死,肉芽组织增生,间质大量急慢性炎症细胞浸润,并见多核巨细胞反应(图3),刚果红染色阳性,抗酸染色阴性。

图2 支气管镜下见黏膜糜烂

图3 右中间支气管黏膜活检病理(HE染色,×100)
电子喉镜检查(2016年2月24日):
慢性鼻咽炎,鼻咽溃疡。
实验室检查:
痰细菌培养见正常菌群生长;尿常规、粪便常规未见异常;C反应蛋白66.40mg/L;血沉67mm/h;血清蛋白电泳正常;血、尿β2微球蛋白正常;血、尿游离轻链正常;尿轻链蛋白电泳:κ轻链37.9mg/L(正常参考值:0~7.10mg/L),λ轻链16.7mg/L(正常参考值:0~3.90mg/L),κ/λ 2.27(正常参考值:0.75~4.50);血轻链蛋白电泳:κ轻链2.15mg/L(正常参考值:5.98~13.29mg/L),λ轻链1.39mg/L(正常参考值:2.69~7.38mg/L),κ/λ 1.55(正常参考值:1.35~2.65);尿特定蛋白:α1-微球蛋白72.6mg/L(正常参考值:0~12mg/L),免疫球蛋白G10.2mg/L(正常参考值:0~9.6mg/L);自身抗体:PR3-ANCA(+++),抗核抗体阳性(1∶320),抗ds-DNA抗体阴性,ENA阴性。
骨髓穿刺:
①骨髓增生活跃,粒细胞系63%,红细胞系21.5%,粒∶红=2.93∶1;②粒细胞系增生,以中、晚幼粒细胞比例增高为主;③红细胞系以中、晚幼红细胞为主,形态正常(图4)。
图4 骨髓涂片(瑞氏染色,×400)
5.初步诊断
①ANCA相关性血管炎可能;②继发性支气管淀粉样变;③双侧急性化脓性中耳炎;④双侧肺炎;⑤鼻窦炎;⑥左侧周围性面神经炎。
6.入院后相关检查
(1)一般检查
血常规:白细胞计数12.5×109/L,中性粒细胞88.4%。血生化:白蛋白35g/L,谷氨酰转移酶59U/L,葡萄糖7.86mmol/L,钾3.2mmol/L,氯96mmol/L,钙2.09mmol/L。C反应蛋白84.50mg/L。血沉65mm/h。凝血功能:纤维蛋白原(Fib)6.09g/L。尿常规:微量蛋白。粪便常规未见异常。
(2)免疫相关检查
CD3细胞计数567/μl,CD4 32.0%,CD4细胞计数220/μl,CD8 39.0%,CD8细胞计数269/μl,CD4/CD8 0.82,NK 10.0%,NK细胞计数84/μl。IgG、补体C3、补体C4正常。
(3)感染相关检查
降钙素原0.12ng/ml。β-D-葡聚糖试验(G试验)、半乳甘露聚糖抗原试验(GM试验)均阴性。T-SPOT 9.0pg/ml。痰培养未见细菌。
(4)肿瘤相关检查
AFP、CEA、CA125、CA199、CYFERA21-1均在正常范围内。
(5)影像学检查
胸部CT:①右肺上叶尖段占位病变,大小约4.0cm×3.1cm,较前明显增大,其内可见空洞;②双侧肺门区及周围新增多发结节状密度增浓影;③纵隔内多发淋巴结肿大(图5)。

图5 胸部CT表现
二、诊治过程
【病例特点】
1.一般情况
患者为中年女性,急性起病,短时间内出现多系统损害。
2.主要症状和体征
首发症状为双耳疼痛、流脓,随后出现发热、咳嗽、咳痰、痰中带血;查体见面神经损害体征,听力下降,双肺可闻及少许细湿啰音。
3.实验室检查
血沉和C反应蛋白显著升高,α1-微球蛋白升高,PR3-ANCA强阳性,抗核抗体低效价阳性。
4.影像学检查
头颅MRI提示双侧乳突炎;胸部CT提示右肺上叶占位病变,双肺多发结节。
5.支气管镜检查
支气管镜下见气管黏膜糜烂;右中叶活检示支气管黏膜肉芽组织增生,间质见大量急慢性炎症细胞浸润,刚果红染色阳性。
6.治疗反应
经甲泼尼龙、头孢哌酮舒巴坦治疗后,患者双耳流脓症状有所缓解,但仍有双耳刺痛、耳鸣、听力下降,且仍发热、咳嗽、咳痰。
【鉴别诊断思路】
◆对于本病例,需考虑哪些疾病可能?
患者为老年女性,急性病程,以双耳疼痛、流脓伴听力下降、面神经麻痹为首发表现,治疗期间出现发热、咳嗽、咳痰、痰中带血,胸部CT提示肺部占位病变,并存在多系统受累,炎症指标高,PR3-ANCA阳性,故应重点考虑ANCA相关性血管炎。
(1)肉芽肿性多血管炎(granulomatosis with polyangiitis,GPA)
患者有上呼吸道、下呼吸道、神经系统、肾脏受累表现,PR3-ANCA强阳性,C反应蛋白、血沉升高,胸部CT提示双肺多发病灶,支气管病理见肉芽组织增生,间质大量急慢性炎症细胞浸润,故考虑为肉芽肿性多血管炎可能性大。
(2)嗜酸性肉芽肿性多血管炎(eosinophilic granulomatosis with polyangiitis,EGPA)
常见表现为哮喘、外周血嗜酸性粒细胞增多和肺部病变。本例患者虽有PR3-ANCA阳性,但无哮喘病史及气促表现,血常规及支气管镜病理均未提示嗜酸性粒细胞增多,故考虑该病可能性不大。
(3)显微镜下多血管炎(microscopic polyangiitis,MPA)
可累及多个脏器,常以肾脏受累为突出表现,多为MPO-ANCA阳性。本例患者虽有呼吸系统症状,但为PR3-ANCA阳性,故考虑该病可能性不大。
◆本病例支气管淀粉样变的原因是什么?
本例患者经支气管活检肺组织刚果红染色阳性,提示存在淀粉样变,病变原因可能如下:
(1)继发性淀粉样变
结缔组织病:是引起继发性淀粉样变的常见原因。其中,类风湿关节炎为最常见病因(发生率约在5%),系统性红斑狼疮、干燥综合征等引起的淀粉样变也时有报道。本例患者有中耳炎、鼻咽部溃疡,头颅MRI提示存在乳突炎症,PR3-ANCA阳性,胸部CT见多发结节影,故考虑ANCA相关性血管炎引起的继发性淀粉样变可能性最大。
肿瘤:特别是多发性骨髓瘤,引起继发性淀粉样变。多发性骨髓瘤继发淀粉样变的发生率在6%~15%。此外,甲状腺髓样瘤等其他肿瘤也可能出现淀粉样变。本例患者肿瘤标志物、血和尿轻链蛋白检测未见异常,骨髓涂片未见恶性细胞,但肺部占位病变性质未明,不排除肺癌可能,故目前尚不能排除肿瘤继发的淀粉样变可能,需进一步检查辅助诊断。
遗传性淀粉样变:如遗传性淀粉样变周围神经病(hereditary amyloid polyneuropathy,HAP),主要是后神经节、自主神经节和周围神经远端有大块类淀粉样浸润,也可出现多系统类淀粉样沉积,多呈家族分布。本例患者家族中无类似病史,无近亲结婚史,故考虑为该病可能性不大。
(2)原发性淀粉样变
确诊需排除继发性因素。本病例目前考虑为肉芽肿性多血管炎可能性大,存在继发因素,故暂不考虑原发性淀粉样变。
【诊治措施】
1.入院后相关诊治
继续予甲泼尼龙(40mg,每天1次)、头孢哌酮舒巴坦(3g,每12小时1次)抗感染,卡马西平镇痛治疗,患者仍持续发热,体温最高达39.5℃,伴畏寒、咳嗽、咳少许白黏痰、双耳及面部针刺样疼痛。影像学检查提示肺部病变较前明显加重。对于治疗效果不佳,考虑有以下可能:
(1)血管炎活动期
患者存在多系统受累,ANCA抗体强阳性,炎症指标明显升高,提示病情较为严重,常规量激素治疗1个月,症状没有缓解,病情继续进展,应考虑激素剂量不足,血管炎疾病仍在活动期的可能,可加大激素剂量,或采取大剂量激素冲击治疗,并加用免疫抑制剂改善病情。
(2)感染加重
患者有咳嗽、咳痰症状,伴反复发热、肺部少许湿啰音,结合胸部影像学检查结果,有发生肺炎的可能性,但用头孢哌酮舒巴坦治疗后患者仍有发热,说明抗感染治疗无效,基本排除了感染的可能。
(3)肿瘤
经激素抗炎及抗菌药物抗感染治疗,复查胸部CT提示肺部肿块增大,肿瘤标志物检查均为阴性,2016年3月11日在CT引导下行右肺上叶病灶经皮肺穿刺活检,病理检查镜下见大片坏死,周边伴组织细胞聚集及多核巨细胞反应,间质中见慢性炎症细胞浸润,纤维组织增生(图6),符合肉芽肿性多血管炎改变。

图6 右肺上叶活检病理(HE染色;A.×100;B.×400)
综上分析,考虑本病例为肉芽肿性多血管炎活动期,给予甲泼尼龙(500mg/d×3天,共两轮)冲击治疗以及环磷酰胺(200mg,隔天1次,共15次)免疫抑制治疗,后续以甲泼尼龙(40mg/d)、环磷酰胺(50mg,每天1次)维持。
第一次冲击治疗后复查:
血沉42mm/h,C反应蛋白8.10mg/L。胸部CT:右肺上叶尖段占位病变较前明显缩小,双侧肺门区及周围多发结节状密度增浓影较前有所缩小,纵隔内多发小淋巴结较前有所缩小(图7)。

图7 第一次冲击治疗后复查胸部CT表现
第二次冲击治疗后复查:
血沉23mm/h,C反应蛋白8.94mg/L。胸部CT:右肺上叶尖段占位病变较前明显缩小,双侧肺门区及周围多发结节状密度增浓影较前有所缩小,纵隔内多发小淋巴结较前有所缩小(图8)。

图8 第二次冲击治疗后复查胸部CT表现
2.最终诊断
①肉芽肿性多血管炎;②继发性支气管淀粉样变;③双侧急性化脓性中耳炎;④双侧肺炎;⑤鼻窦炎;⑥左侧面神经炎。
【临床转归】
经上述治疗后,患者体温恢复正常,无咳嗽、咳痰、双耳疼痛及面部疼痛,于2016年4月20日出院。出院后,患者于门诊规律随诊,截至2017年3月底,甲泼尼龙减至8mg/d,环磷酰胺为(50mg,每天1次)维持。复查血沉4mm/h,C反应蛋白<0.789mg/L。胸部CT示双肺斑片状、条索影,右肺上叶尖段、双侧肺门区及周围多发结节已吸收(图9)。

图9 胸部CT:肺部多发结节已吸收
【临床难点】
肉芽肿性多血管炎(granulomatosis with polyangiitis,GPA)既往称韦格纳肉芽肿,临床表现复杂多样,一般多以呼吸道症状起病,典型表现包括上呼吸道、下呼吸道和肾脏受累表现(三联征)。本病例以中耳炎为首发表现,伴有发热、面神经损害,胸部影像学检查示肺部多发病灶伴空洞样改变,支气管镜检查见支气管黏膜溃疡改变,肺活检病理示淀粉样变,不完全符合典型GAP表现,对明确诊断造成一定影响。这就需要临床医师在临床诊疗过程中提高对该病的甄别意识,否则会延误诊断,影响预后。
三、点睛析评
系统性血管炎是众多风湿病中的疑难疾病,临床表现错综复杂。本病例以耳部损害为首发突出症状而就诊于耳鼻喉专科,诊治过程较为曲折,经临床、影像、病理多学科交流和综合分析判断,方明确诊断。另外,患者对常规剂量激素治疗反应欠佳也影响了临床判断。最终临床医师在对患者及其疾病充分了解后大胆决策,调整治疗方案,取得良好效果。
知识来源
人卫知识数字服务体系
- 评价此内容
- 我要打分
近期推荐
热门关键词
最新会议
- 2013循证医学和实效研究方法学研讨会
- 欧洲心脏病学会年会
- 世界帕金森病和相关疾病2013年会议
- 英国介入放射学学会2013年第25届年会
- 美国血液学会2013年年会
- 美国癫痫学会2013年第67届年会
- 肥胖学会 2013年年会
- 2013年第9届欧洲抗体会议
- 国际精神病学协会 2013年会议
- 妇科肿瘤2013年第18届大会
- 国际创伤压力研究学会2013年第29届…
- 2013年第4届亚太地区骨质疏松症会议
- 皮肤病协会国际2013年会议
- 世界糖尿病2013年大会
- 2013年国际成瘾性药年会
- 彭晓霞---诊断试验的Meta分析
- 武姗姗---累积Meta分析和TSA分析
- 孙凤---Network Meta分析
- 杨智荣---Cochrane综述实战经验分享
- 杨祖耀---疾病频率资料的Meta分析
合作伙伴
Copyright g-medon.com All Rights Reserved 环球医学资讯 未经授权请勿转载!
网络实名:环球医学:京ICP备08004413号-2
关于我们|
我们的服务|版权及责任声明|联系我们
互联网药品信息服务资格证书(京)-经营性-2017-0027
互联网医疗保健信息服务复核同意书 京卫计网审[2015]第0344号




会员登录

